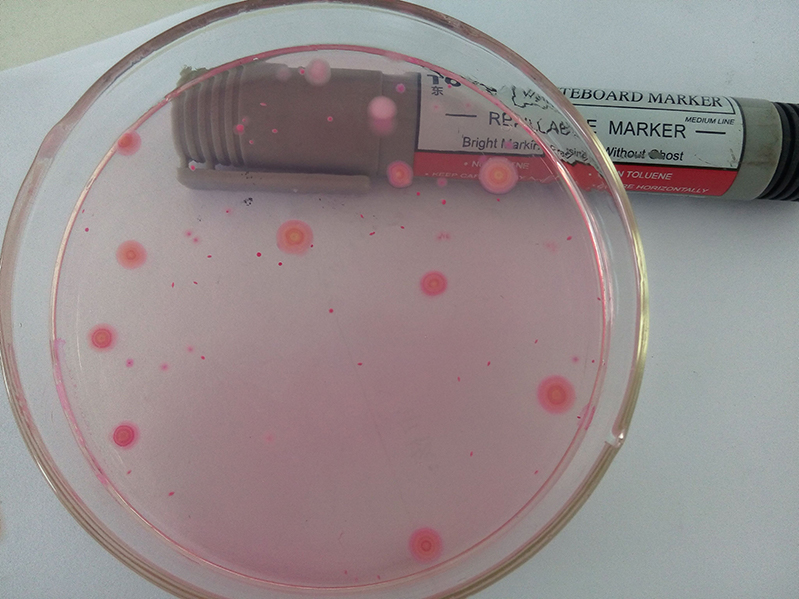
ATP熒光檢測器

如果您正在尋找相關產品或有其他任何問題,可隨時撥打公司服務熱線,或點擊下方按鈕與我們在線交流!
服務熱線:13371098225
咨詢客服

如果您正在尋找相關產品或有其他任何問題,可隨時撥打公司服務熱線,或點擊下方按鈕與我們在線交流!
ATP熒光檢測器是我們生活中常見的設備。眾所周知,細菌在我們的生活中無處不在,但有些細菌對我們有益,有些細菌會影響我們的健康。這種儀器也叫細菌檢測儀,可以快速檢測細菌。
ATP三磷酸腺苷是一種不穩定的高能化合物。在活細胞中,可以轉化為ADP,實現能量儲存和釋放,從而保證細胞所有生命活動的能量供應。保證食品在生產、加工和制造過程中的安全非常重要。如果食品衛生條件不達標,食品安全就會有一定的安全隱患。如果食品和飲料行業的衛生條件差,蒼蠅和其他微生物感染食物是很常見的。人們吃了這種食物后會腹瀉或患其他疾病。工商部門經常檢查餐飲業的衛生狀況,但這只是表面現象。還有一些微生物可以用ATP熒光檢測器檢測出來,可以檢測出我們看不見摸不著的細菌和病毒,保證了食品生產環境。

該儀器可以快速測定微生物含量,因此食品安全和相同的食品生產環境應引起重視。此外,它可以促進創造一個健康的食品生產環境。防止細菌和病毒流入人們的餐桌,從而保證每個人的健康。綜上所述,ATP熒光檢測器的使用非常重要,在微生物檢測中發揮著非常廣泛的作用。它的應用更好地保證了我們舌尖的安全,從而保證了我們的食品購買。
手機: 13371098225
地址:山東省濰坊高新區新城街道玉清社區光電產業加速器 (一期)1號樓
Copyright @ 2019-2022 山東云唐智能科技有限公司 All Rights Reserved. 版權所有 農藥殘留檢測儀 食品檢測儀 細菌檢測儀源頭廠家
 微信
微信
